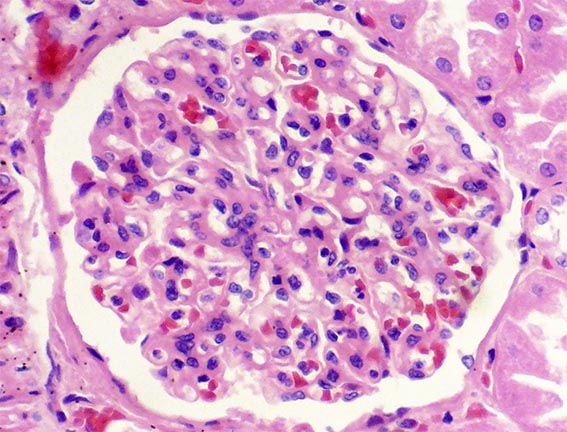

|
|
CASO
108 (Febrero 2015)
Datos clínicos:
El paciente es un hombre de 39 años de edad evaluado por presentar varios meses de malestar general, fiebre subjetiva intermitente, dolor abdominal y melenas. En paraclinicos se documenta leve anemia, leucocitos normales, pruebas de autoinmunidad normales o negativas. Creatinina sérica: 3,2 mg/dL, BUN: 41 mg/dL. Uroanálisis: proteinuria: 150 mg/dL, eritrocitos en el sedimento: 20-30 /CGA, con escasos cilindros granulares.
Observe las imágenes:

Figura 1. H&E, X100.

Figura 2. H&E, X200.

Figura 3.
H&E, X200.

Figura 4. H&E, X100.

Figura 5.
H&E, X400.

Figura 6. H&E, X200.

Figura 7. H&E, X200.
Figura 8.
H&E, X400 (corte grueso; no o leve hipercelularidad).

Figura 9. H&E, X200.

Figura 10. H&E, X200.
¿Cuál es su diagnóstico?
Ver
diagnóstico y discusión
[Arriba]
|
|